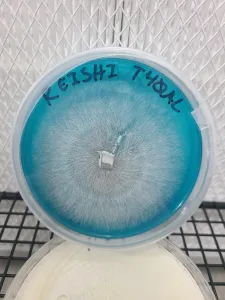
A petri dish labeled 'Reishi T400AL' with blue-tinted agar and dense radial mycelium growth.
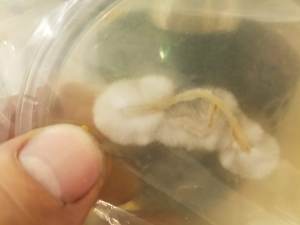
A tissue clone from a grocery store mushroom growing on an agar plate.

Mushroom cultivation is an exciting process, but it requires precision and patience to be successful. For both beginners and advanced growers, Malt Extract Agar (MEA) plates are indispensable tools. These nutrient-rich plates provide a controlled environment to monitor and optimize mycelium growth, isolate clean cultures, and clone wild specimens. In this guide, we’ll explore why MEA agar plates are essential, how to use them, and tips to get the most out of them.
Why Use MEA Agar Plates?
MEA plates are a tried-and-true method in mycology, known for their ability to support healthy mycelium growth. Mycelium, the vegetative part of fungi, spreads across the agar medium, feeding on the nutrients provided by malt extract. With agar’s gel-like consistency giving structure to the medium, these plates make it easy to track mycelium development and detect contaminants.
Here are the key reasons why using MEA agar plates is crucial for mushroom cultivation:
1. Early Contamination Detection
Reishi mushroom mycelium spreading radially across a blue agar plate, marked with the identifier ‘T400AL’ for tracking purposes.
Contamination is one of the biggest threats to successful mushroom cultivation. MEA plates allow you to visually inspect mycelium growth and spot contaminants like mold or bacteria early. This ensures you only transfer healthy cultures to grain spawn or bulk substrates, preventing widespread contamination.
2. Strain Isolation and Selection
Working with spores often results in mixed genetics, which means you might end up with a blend of strong and weak mycelium. Agar plates allow you to isolate the most vigorous strains by transferring the healthiest sections of mycelium to fresh plates. This technique, called sectoring, gives you more control over the final results of your grow.
3. Cloning Wild or Store-Bought Mushrooms
Have you ever found an interesting mushroom in the wild or wanted to replicate the performance of a mushroom you bought from the store? Cloning allows you to capture those genetics by transferring a small tissue sample onto an MEA agar plate. This isolates the mycelium in a sterile environment, giving you the chance to grow mushrooms with the same characteristics.
4. Storage and Long-Term Preservation
Cultivators often store viable mycelium on agar plates for later use. MEA plates act as a backup repository of healthy mycelium cultures that can be transferred to new substrates or saved for future experimentation. With proper storage in cool temperatures, these plates can last for several months.
Preparing to Work with MEA Agar Plates
Using agar plates requires a sterile workspace to avoid contamination. Here’s how to set yourself up for success.

A stack of sterile agar plates positioned inside a wooden laminar flow hood, ensuring a clean environment for mycology work.

This image shows the interior of a still air box, featuring stacks of agar plates and tools organized for sterile work. Still air boxes create a controlled environment by minimizing airflow, which helps reduce contamination risks during inoculation, cloning, and transfers in mushroom cultivation.
Tools and Supplies Needed
- Pre-poured or homemade MEA agar plates
- Sterile scalpel or inoculation loop
- Spore syringe or tissue sample
- Parafilm or micropore tape
- Alcohol wipes and isopropyl alcohol (70-90%)
- A still air box or laminar flow hood
- Labels and a marker
A laminar flow hood ensures sterile air movement, but if you don’t have one, a still air box can work well. Always sterilize your tools and hands with alcohol to avoid introducing contaminants.
Step-by-Step Guide to Using MEA Agar Plates
Let’s walk through two main processes: inoculating with spores and cloning tissue samples. These methods will allow you to grow and monitor healthy mycelium on MEA plates.
1. Inoculating MEA Plates with Spores
If you have a spore syringe, inoculating an MEA plate is simple:
- Shake the syringe well to ensure spores are evenly distributed.
- Flame-sterilize the needle until it glows red, and allow it to cool briefly.
- Lift the plate lid slightly, just enough to insert the needle, and dispense a small drop of spore solution onto the agar’s surface.
- Close the lid quickly and seal it with parafilm, micropore tape, or baggies to keep contaminants out.
- Label the plate with the mushroom strain, date, and any other relevant notes.
Place the plate in a dark, room-temperature area (65-75°F / 18-24°C). Mycelium will typically appear within 5 to 10 days, though some species may take longer.
A close-up of a tissue clone from a store-bought mushroom, showing early mycelium growth on an agar plate.
2. Cloning Tissue on Agar Plates
Cloning involves transferring a small piece of mushroom tissue directly onto an MEA plate. This method ensures you capture a specific mushroom’s genetic traits, whether it’s wild or cultivated.
- Open the mushroom to expose the inner flesh. Avoid touching the exterior, as it could carry contaminants.
- Sterilize your scalpel by flaming it until red hot. Let it cool before use.
- Carefully cut out a piece of tissue from inside the mushroom cap or stem.
- Lift the plate lid slightly and place the tissue on the agar surface.
- Seal the plate with parafilm or micropore tape and label it with the mushroom variety and date.
After a few days, you’ll see mycelium spreading from the tissue. Monitor for any contaminants and prepare to transfer clean sections of mycelium if needed.

A yellow circle marks the section of healthy mycelium growth amidst contamination on an agar plate.
Monitoring and Troubleshooting Growth
As your MEA plates incubate, you’ll need to inspect them regularly for mycelium growth and contamination. Here’s what to look for:
- Healthy Mycelium: Appears white and fluffy, with even growth patterns.
- Contaminants: Mold can appear green, black, or gray, while bacteria often looks slimy or discolored.
If contamination occurs, use a sterile scalpel to transfer a clean section of mycelium to a new plate. This process, called sectoring, isolates healthy mycelium, giving it a better chance to thrive.
Tips for Success
- Keep Handling to a Minimum: Each time you open a plate, you increase the risk of contamination. Work efficiently and avoid unnecessary handling.
- Label Everything Clearly: Agar work can involve multiple strains and transfers. Labeling ensures you keep track of each plate’s contents.
- Store Plates Properly: Keep unused plates sealed in plastic bags and store them in a cool, dark place to prevent them from drying out.
- Practice Sterile Technique: Flame sterilize your scalpel or needle between uses and wipe down surfaces with alcohol to maintain a clean environment.
Frequently Asked Questions
Q: How long can I store agar plates with mycelium?
A: MEA plates with healthy mycelium can be stored for several months if kept at cool temperatures (around 39°F / 4°C). For longer storage, consider using slants or transferring mycelium to grain jars.
Q: Can I make my own MEA plates at home?
A: Yes! You can buy malt extract and agar powder separately, mix them with water, and pour the solution into sterile Petri dishes. However, pre-poured plates from Seismic Spore save time and reduce contamination risks.
Q: How do I know if my plate is contaminated?
A: Contaminants are often easy to spot—they usually appear as patches of color (green, black, or yellow) or slimy textures. Healthy mycelium should look white and uniform.
Conclusion
are an essential tool for anyone serious about mushroom cultivation. Whether you’re testing spores for contamination, isolating strains, or cloning wild mushrooms, agar plates give you the control and precision needed for successful cultivation. At Seismic Spore, we provide pre-poured MEA plates to make your mycology journey smoother. With practice, using agar will become second nature and significantly improve your results.
Investing in MEA plates not only reduces contamination risks but also ensures you work with the healthiest cultures possible. Try them out today and see the difference it makes in your cultivation process!




0 Comments